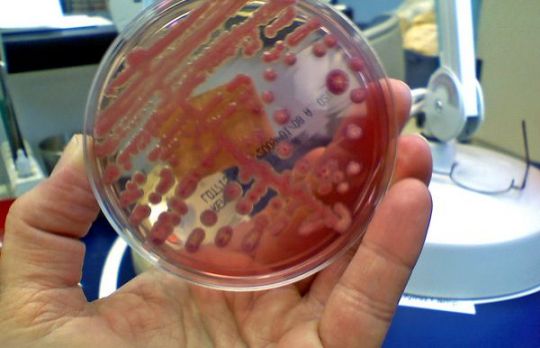
Ce este si cum se face urocultura

Ai dureri de scalp? Iata ce le cauzeaza si cum poti scapa de ele
8,424
Vrei sa afli mai multe informatii despre o boala anume? Vrei sa afli ce tratamente sunt indicate? Noi iti punem la dispozitie o lista intreaga cu remedii, insa decizia de a aplica un tratament o iei doar dupa indicatiile medicului!